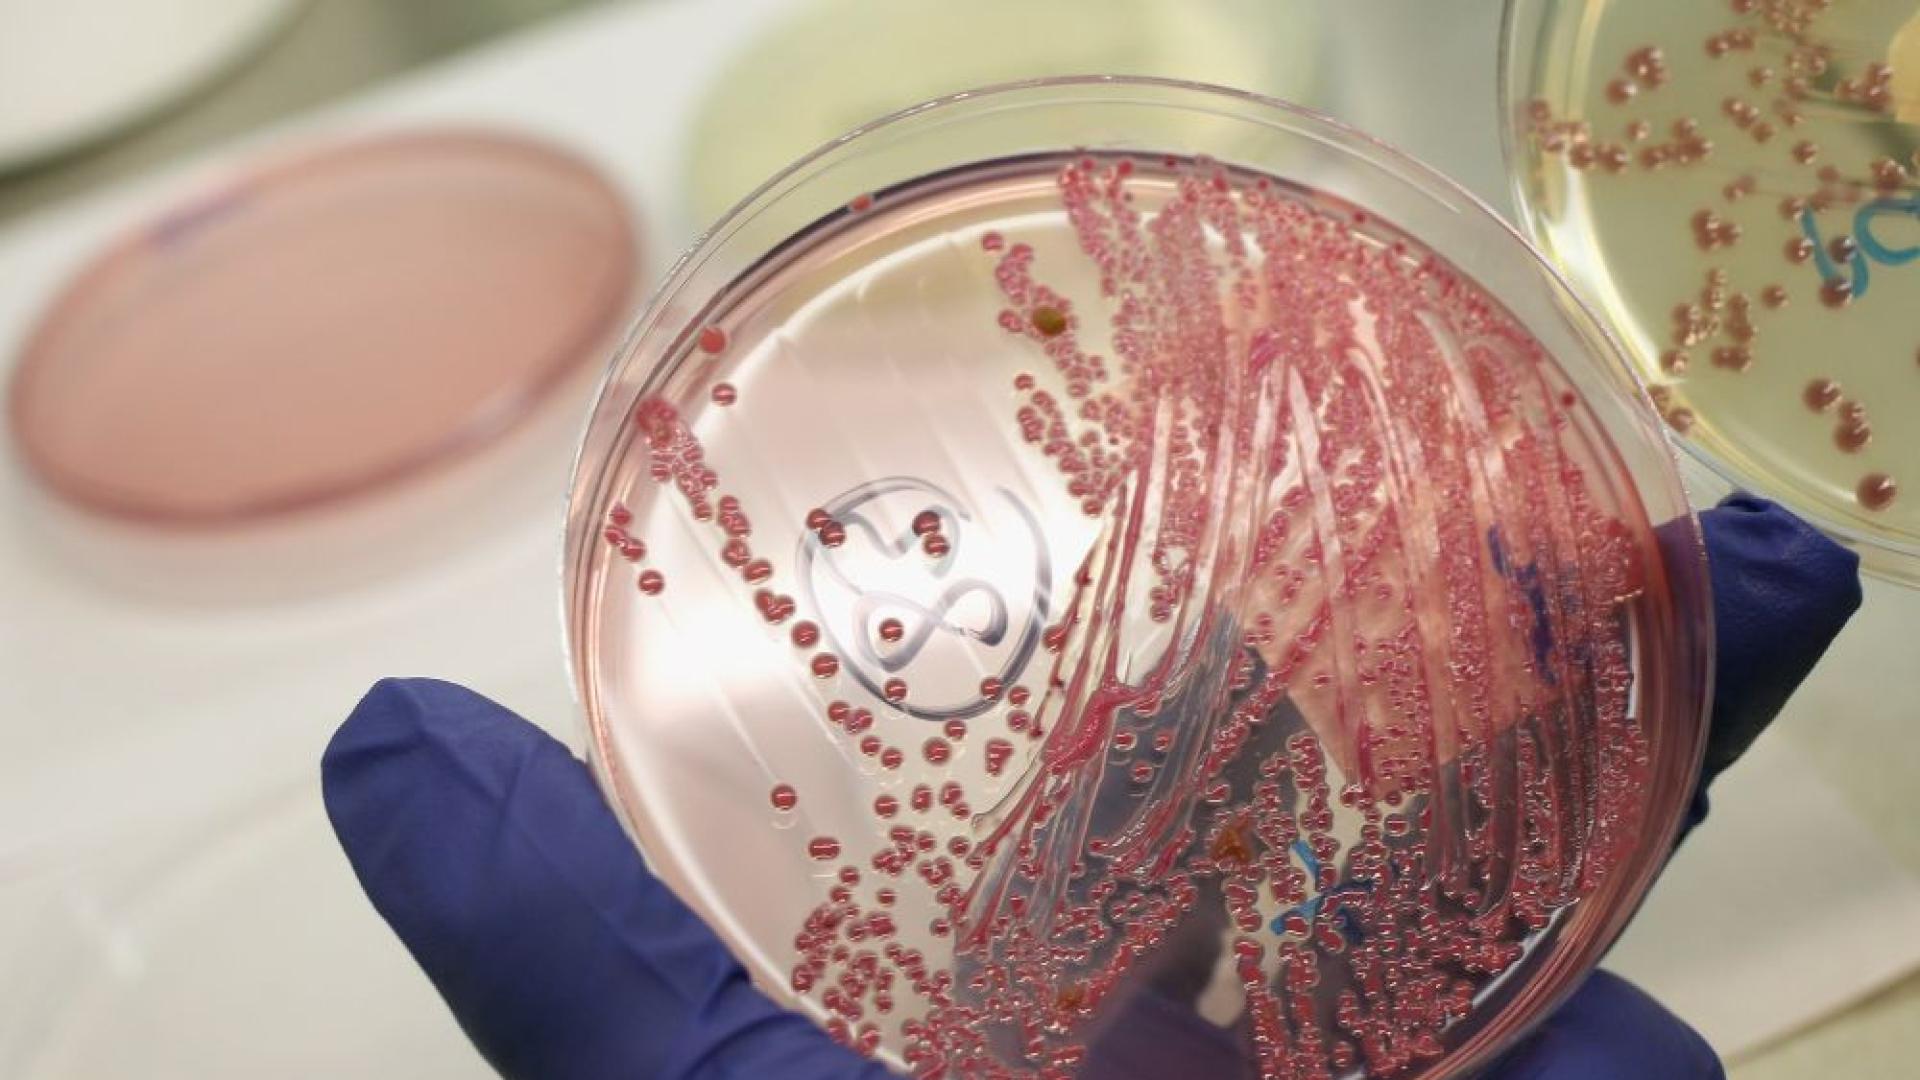
Учените искат да използват бактериите живеещи в червата и устата

... британското правителство за здраве, професор Дам Сали Дейвис заяви, че устойчивостта на бактериите към антибиотици представлява заплаха за човечеството подобна на глобалното затопляне и тероризма.
Бактериите - Новини
СЗО алармира Бактериите стават устойчиви на антибиотици – задава се
...... употреба;по-добра хигиена и превенция на инфекциите.„Ако не действаме сега, рискуваме да се върнем в епоха, в която обикновена инфекция може да бъде смъртоносна,“ предупреждават от организацията.
Бактериите бързо развиват резистентност към антибиотици и тя вече е
...... от такива случаи може да се увеличи със 70% до 2050 г.Световната здравна организация отправя спешен призив за повече проучвания и разработване на нови антибиотици.
Бактериите развиват тревожна устойчивост към антибиотиците – това показва ново
...... хигиена и превенция на инфекциите. „Ако не действаме сега, рискуваме да се върнем в епоха, в която обикновена инфекция може да бъде смъртоносна,“ предупреждават от организацията.
Учени от NYU Langone Health и Perlmutter Cancer Center установиха
...... – може да помогне не само за предотвратяване на пародонтоза, но и за намаляване на риска от рак“, добави д-р Ричард Хейс, съавтор на изследването.
Пети човек е починал след като се зарази с редки
...... Политика. Бюленти ProDcastsDownload нашата компания AppBrand Studiositemap за ParamountAdvertise с Paramountjoin на нашия талант CommunityHelpfeedback Copyright © 2025 CBS Interactive Inc. Всички права запазени. Преглед
Учените искат да използват бактериите живеещи в червата и устата
...... часовите зони, определени кариери и начин на живот, както и заболявания, свързани с възрастта. Има потенциал много хора да се възползват от него“, казва Райт.
Преди грипния сезон Най мощните природни антибиотици които убиват бактериите за
...... заменят напълно лекарствата, но са отлична превенция и подкрепа за имунната система. Включете ги в менюто си и се насладете на по-здравословен начин на живот.
Ню Йорк AP държавите предупреждават плажовете за лятното прилив на инфекции
...... прес получава подкрепа от отдела за научно образование на Медицинския институт Хауърд Хюз и Фондация Робърт Ууд Джонсън. AP е единствено отговорен за цялото съдържание.
Ако оцетът е в големи количества обаче може да повредим
...... което ще ви помогне да избегнете проблемите с мухъла, е винаги да оставяте вратата отворена след използване на машината - тя трябва да изсъхне напълно.
Борбата с патогените изисква бърза и прецизна реакция от страна
...... механизми открива път за нови терапевтични подходи, позволяващи по-фино медикаментозно моделиране на имунната реакция — както при инфекции, така и при автоимунни и онкологични състояния.
SpaceX стартира своята мисия на Crew 11 в Международната космическа станция
...... и бактериалната физиология в общата. След растеж при микрогравитация. Молекулярният и транскрипционният анализ и директното сравнение с бактериите, отглеждани едновременно в еднаква лаборатория на земята.
Кофеинът може да помогне на определени бактерии да блокират проникването
...... дали този ефект се проявява при други видове микроби. Към момента няма причина за тревога сред консумиращите кофеин, но темата остава актуална за бъдещи изследвания.
Здравни експерти от Турция предупреждават за наличието на опасните бактерии
...... черния дроб вследствие на хепатит, чернодробно заболяване или прекомерна консумация на алкохол или наркотици. Хората с рак, диабет или ХИВ също принадлежат към рисковата група.
Повечето собственици на автомобили обръщат голямо внимание на външното почистване
...... се препоръчва периодично да се прави сериозно почистване, като се обръща специално внимание именно на багажника, седалките и таблото, като се използват подходящи дезинфекциращи препарати.
бактериите на червата се считат за ключов фактор при много
...... специфични бактериални цели за лечение или диетични интервюта, които всъщност биха могли да помогнат на пациентите, да се движат от основни изследвания към практически приложения.
Колко често почистваме интериора на колата си честно В най добрия
...... и на физиологичното състояние на седящите вътре. Редовната поддръжка на гореспоменатите зони помага за намаляване на количеството бактерии и същевременно подобрява цялостната хигиена на интериора.
Колко често почистваме интериора на колата си честно В най добрия
...... и на физиологичното състояние на седящите вътре. Редовната поддръжка на гореспоменатите зони помага за намаляване на количеството бактерии и същевременно подобрява цялостната хигиена на интериора.
В ерата на парогенератори минимализъм и модерни тъкани гладенето все
...... не е зле да преосмислим ролята ѝ - не като домашно наказание, а като малък ритуал, който има повече ползи, отколкото сме склонни да признаем.
В ерата на парогенератори минимализъм и модерни тъкани гладенето все по често
...... не е зле да преосмислим ролята ѝ – не като домашно наказание, а като малък ритуал, който има повече ползи, отколкото сме склонни да признаем.
В ерата на парогенератори минимализъм и модерни тъкани гладенето все по често
...... не е зле да преосмислим ролята ѝ – не като домашно наказание, а като малък ритуал, който има повече ползи, отколкото сме склонни да признаем.
Регистрирайте се за бюлетина за научна теория на CNN
...... когато се опитвате да изградите инфраструктура за общност, която наистина се нуждае от нея, или ако се опитвате да изградите инфраструктура в космоса, този m
Правилната бактериална флора е ключът към здравата кожаВ света на
...... срещу екземи.Учените са все по-убедени, че бъдещето на дерматологичното лечение е свързано с използването на полезни бактерии вместо с тяхното унищожаване чрез антибиотици и дезинфектанти.
Бризбейн Цюрих На земята има приблизително трилион вид микроорганизми по
...... на Creative Commons. Прочетете оригиналната статия. (с изключение на заглавието, тази история не е редактирана от служителите на NDTV и е публикувана от синдикирана емисия.)
Американски учени от университета Джонс Хопкинс са открили че бактериите
...... до създаването на терапии с фаги, които използват вируси за унищожаване на опасни бактерии. Предишно изследване установи, че бактериите убиват конкурентите си с помощта на вируси.
Американски учени от университета Джонс Хопкинс са открили че бактериите
...... до създаването на терапии с фаги, които използват вируси за унищожаване на опасни бактерии. Предишно изследване установи, че бактериите убиват конкурентите си с помощта на вируси.
Бактериите са най честата причина за пневмония при възрастни Много видове бактерии
...... вашето семейство да не получите пневмония. Ваксината за грип обикновено се дава през септември до ноември преди месеците, в които най-често се разпространява грипния вирус.
Изследователи от Токийския столичен университет са създали наноструктурирани повърхности от алуминиев
...... Вие можете да допринесете за нашия стремеж към истината, неприкривана от финансови зависимости. Можете да помогнете единственият поръчител на съдържание да сте вие – читателите.
Изследване публикувано в научното списание Сайънс разкрива че бактерията Стафилококус
...... на антибактериални препарати. Ефективното справяне с антимикробната резистентност ще изисква глобално сътрудничество, научни изследвания и осведоменост. Грипът дебне! Ключови стъпки за защита и разпознаване на симптомите
Бактериите бързо успяват да развият резистентност към нови антибиотици сочи
...... е огромна заплаха за общественото здраве, а съгласно скорошен доклад около 40 милиона души годишно ще умират заради причинени от нея инфекции към 2050 година.
До 5 от хората които се подлагат на операция могат
...... екипа за начин на живот във Fox News Digital. Съвети за истории могат да се изпращат на [email protected].Свързани темиЗДРАВЕБактерииХирургияЗдравеопазване МЕДИЦИНСКИ ИЗСЛЕДВАНИЯ СТИЛ НА ЛАЙФА ТЕХНОЛОГИИ
Учени от Чикагския университет и Калифорнийския университет в Сан Диего
...... на безопасността и ефективността на това лечение, учените биха могли да разработят носима лепенка с безжична верига за контролиране на инфекциите без лекарства, заключи Тиан.
Жените триатлонистки се гмурнаха от син понтон в Сена в
...... спечели злато със силно представяне в бягането на 10 км, изпреварвайки Хейдън Уайлд от Нова Зеландия, която спечели сребро . Французинът Лео Бержер спечели бронза.
Бактериите често се срещат в устата и в лабораторни изследвания
...... обаче трябва да бъде балансирано от известната им роля за влошаване на раковите заболявания, като тези в червата."Проучването е описано подробно в списанието Cancer Communications.
От сцинковете сияещи в различните цветове на дъгата до ослепителните
...... ни позволи да разработим екологични материали с трайни цветове и други желани свойства, като например леки бои за самолети. Изследването е публикувано в PNAS. Източник: Science Alert
Кметът на Париж Ан Идалго се потопи в река Сена
...... по откриването на Олимпийските игри в Париж е на 26 юли. Джулен Чавин, Джоузеф Атаман, Саманта Тапфуманей и Били Стокуел от CNN допринесоха за репортажите.
Осем бебета са починали досега тази година от магарешка кашлица
...... родителите също трябва да гарантират, че децата им са защитени през първите няколко месеца след раждането като част от рутинното предложение за ваксина на NHS.“
Учени разкриват бактериите предизвикващи затлъстяванеКитайски учени идентифицираха бактерии които предизвикват
...... са свързани с телесното тегло,обиколката на талията и индекса на телесната маса. Поради това изследователският екип установява значителна връзка между Megamonas и затлъстяването, отбелязва Синхуа.
Учените са разработили самосмилаща се пластмаса която според тях може
...... че трябва да се тревожим по-малко за замърсяването на околната среда с пластмаса“, каза той пред Би Би Си.Изследването е публикувано в списанието Nature Communications.
През месец ноември 1998 г четиринадесет държави от целия свят
...... доста плашещо: няма никаква гаранция, че може да се появи някаква съвсем нова и неуязвима бактериална мутация, с която не бихме могли да се справим.
Спокойно може да се консумират всички плодове и зеленчуци които
...... е ролята на съвестните фермери, на контролните органи да тестват постоянно месото, местните и млечните продукти,“ категоричен е д-р Сергей Иванов от Асоциация "Активни потребители".
Според ново изследване едноклетъчен организъм без мозък или нервна система
...... крайна сметка колкото повече знаем за поведението на бактериите, толкова по-лесно е да се борим с тях”, заключава Бхатачария. Изследването е публикувано в PNAS. Източник: Science Alert
Вкрая на януари и началото на февруари се наблюдава висока
...... е заместител на разнообразното хранене. Да се държи далеч от деца. Номер и дата на вписване в регистъра на добавките - Рег. № Т222104289и 07.12.2021 г.
Между безкислородната атмосфера излагането на радиация и липсата на хранителни
...... да придружават хората, но могат да бъдат и сериозен проблем за нас, докато сме там, прави последиците много по-сериозни.Резултатите са публикувани в списание Astrobiology.По темата
Невероятен 35 годишен експеримент разкрива сложността на еволюционния процес Американският биолог Ричард
...... избора на антибиотици за предотвратяване на резистентността при бактериите. Изследванията им подчертават значението на разбирането на еволюционните процеси за решаване на медицинските и биотехнологичните предизвикателства.
Учените са открили изцяло нов клас антибиотици които убиват една
...... като, за да влязат в клинични изпитвания, те трябва да бъдат произведени по определени стандарти, но инвестициите в производствените предприятия зависят от успешните клинични изпитвания.